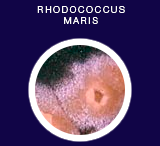
Rhodococcus maris
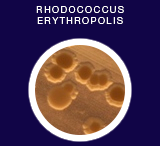
Rhodococcus erythropolis

ПетроклинерTM
до 1998 года производился и использовался под названием «Деворойл»
эффективный микробиологический препарат для биодеградации нефтепродуктов
наряду с другими разработками компании «Экосинтез», неоднократно экспонировался на международных и отечественных выставках, награжден медалью и почетным дипломом ВДНХ, рекомендован к применению Министерством охраны окружающей среды и природных ресурсов России (приказ № 200 от 27.06.94 г.)
эффективно очищает от нефти и нефтепродуктов

Поверхности пресноводных и морских водоемов

Нефтяные и буровые шламовые амбары

Замазученные земельные участки
состав препарата

Сбалансированный состав препарата обеспечивает эффективное разложение нефти и нефтепродуктов,
безопасную
и нетоксичную утилизацию отходов в широких диапазонах температур как в природных
условиях, так и на
промышленных объектах.
свойства препарата

Способен действовать в широком диапазоне температур (+5...+37°C), устойчив к резким колебаниям температуры.

Способен действовать в широком диапазоне кислотности среды (pH4,5—9,5), приспособлен к средам с соленостью до 150 г/л и значительному химическому загрязнению среды.

Может очищать почву с загрязненностью нефтью и нефтепродуктами свыше 20 г/куб.м и воду, содержащую более 5% нефти и нефтепродуктов.

Прост в применении: нанесение суспензии препарата с помощью подвижных механизированных средств, оборудованных распылительными устройствами.
подробная информация о свойствах препарата в pdf
уникальная механика действия препарата
объясняется физиологическими свойствами составляющих его микроорганизмов




изменение Состояния почвы и воды
Обработка почвы и воды препаратом оказывает положительное влияние на процессы самоочищения: улучшается внешний вид и процессы аэрации.
В почве

поверхность воды освобождается от пленки нефти, улучшаются процессы аэрации, восстановливаются процессы самоочищения, вода не приобретает токсичных свойств, не нарушаются процессы минерализации.
В водоемах

ускоряется восстановление самоочищающейся способности (освобождение от фекальных загрязнении, ЛКП, термофилов), улучшается биологическая ее полноценность.
эффективность препарата апробирована с 1993 года следующими организациями
"Правдинскнефть""Башнефть" депо "Иваново""Тюменбургаз" "Юганскнефтегаз""Ноябрьскнсфтегаз"ТЭЦ АО "Ленэнерго""Астраханьбургаз« «Заполярнефть» ж.д. станция "Челябинск"Калининская АЭС"Кондпетролеум" "Барсуковнефть"ж.д. станция "Рыбинск«Металлургический комбинат им. ДзержинскогоАО «Роснефть» "Когалымнефть«ж.д, станция «Перово» Московской ж.д."Севербургаз«АО «Газпром»имеются акты на проведенные работы
Разрешительная документация
Имеется вся разрешительная документация на применение данного препарата. Микробиологический препарат для борьбы с нефтяными загрязнениями (разрешен к применению: Госкомитет санэпидемнадзора № 01-13/1102-11 от 29.08.95 г.
Госэкспертиза Минприроды России № 11-32/237 от 20.04.95 г. и № 19-1/20-664 от 19.12.97 г. В соответствии с приказом Минприроды России от 20.04.94 г. № 114 проведена государственная экологическая экспертиза материалов по применению данного микробиологического препарата для очистки почв и водоемов от загрязнения нефтепродуктами. Экспертная комиссия в составе председателя — академика РАН С.В.Яковлева и её членов: д.т.н. А.А.Бондарева, д.х.н. П.А. Гембицкого, д.х.н. Д.А.Топчиева, к.т.н. Д.А.Каушанского, к.б.н. Т.П.Ступаковой пришла к выводу, что препарат можно рекомендовать для применения в народном хозяйстве для очистки от нефти и нефтепродуктов почв и водоемов.